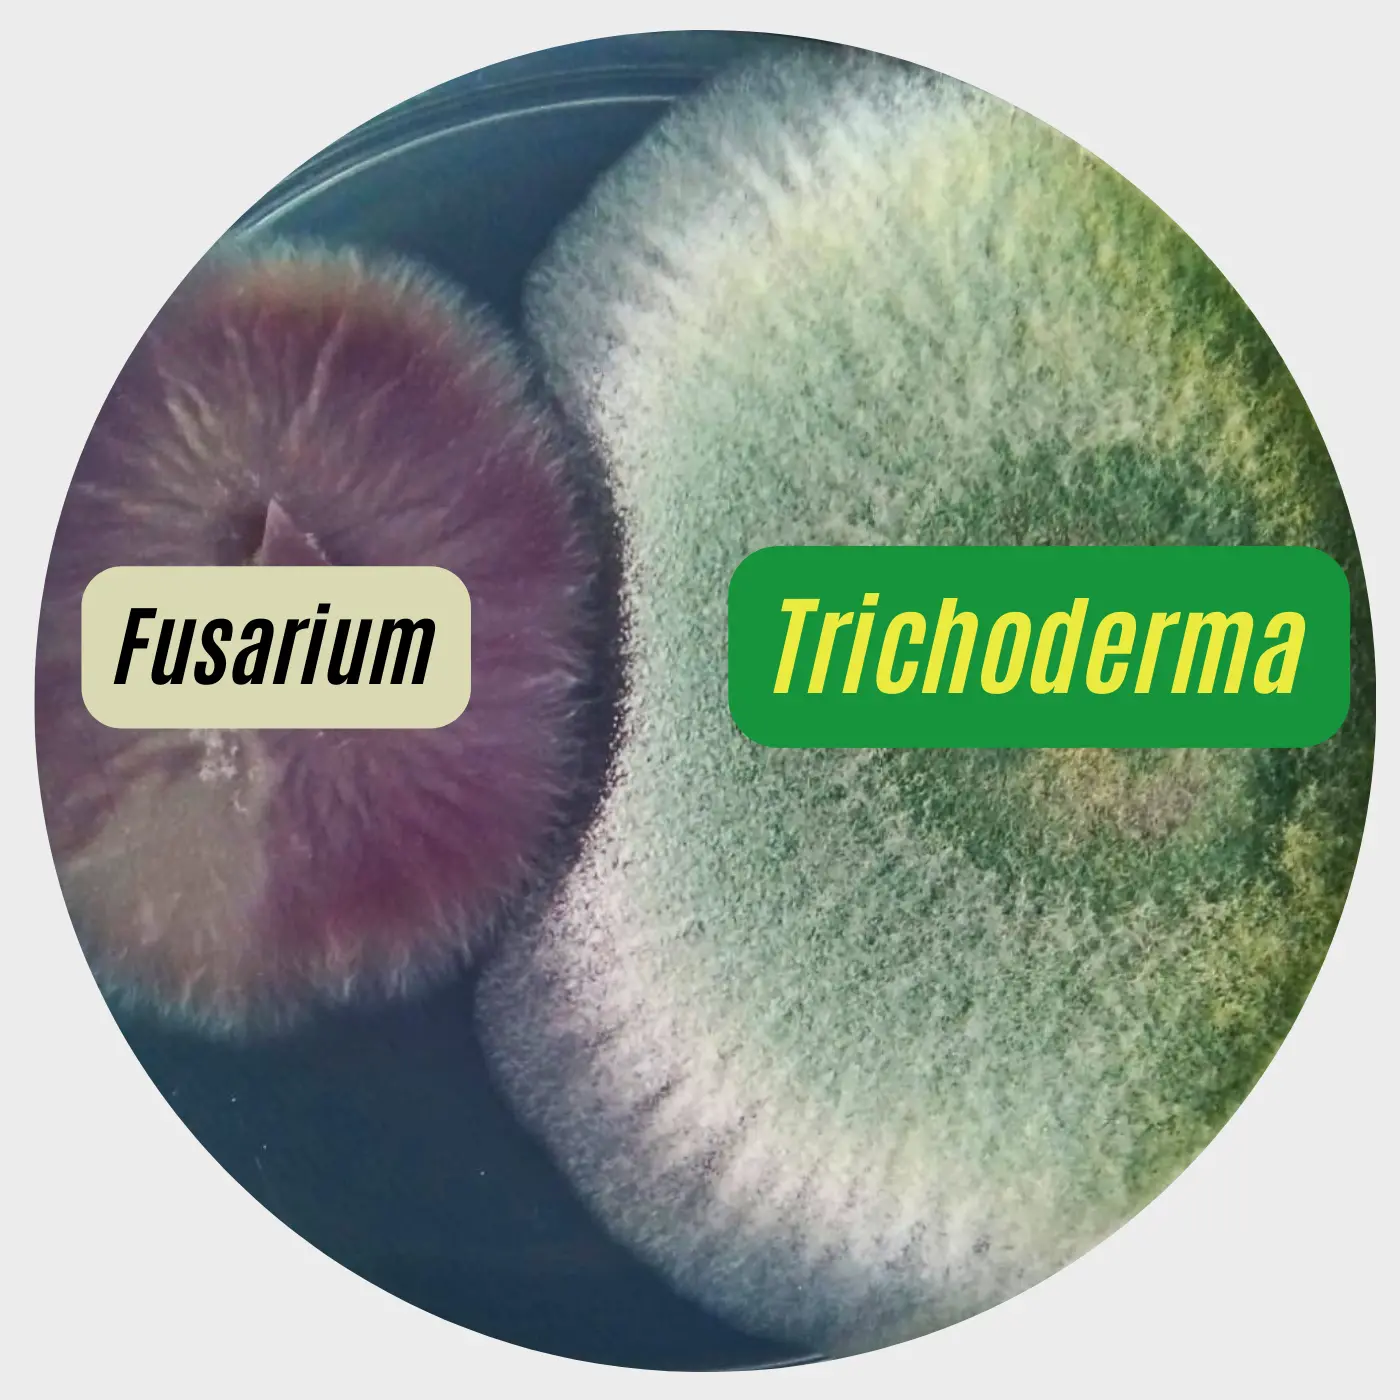

La producción sostenible de agave tequilana es un desafío cada vez mayor. Con la demanda creciente de tequila, los productores enfrentan problemas críticos que pueden afectar tanto la calidad del agave como la eficiencia de la producción. La pregunta es, ¿cómo lograr cultivos saludables y productivos sin comprometer la sostenibilidad del suelo y los recursos? Aquí es donde entran los bioestimulantes y agentes de biocontrol. Desde la raíz hasta el corazón de cada planta, el hongo Trichoderma protege, fortalece y estimula el crecimiento del agave azul de manera natural. Sigue leyendo para descubrir cómo nuestros productos Fertiatro y Atromix MS están transformando el cultivo del agave.
La Marchitez del Agave y Otros Retos en la Producción Sostenible de Agave Tequilana
Para quienes cultivan agave tequilana, la marchitez del agave es una de las amenazas más devastadoras. Este problema es causado por patógenos como Fusarium y Thielaviopsis paradoxa, que debilitan la raíz y provocan un debilitamiento generalizado en la planta. Además, el cultivo enfrenta el reto de cómo aumentar el tamaño y peso del agave, factores clave para obtener un mejor rendimiento en cada cosecha. Estas necesidades han llevado a los productores a explorar alternativas sostenibles que no solo mantengan la salud del suelo, sino que también protejan las plantas de plagas y enfermedades.
Aquí es donde productos como Fertiatro, un agente de biocontrol, y Atromix MS, un bioestimulante a base de metabolitos secundarios de Trichoderma, se presentan como soluciones efectivas y naturales que responden a estos desafíos.
¿Por qué elegir Trichoderma para la producción sostenible de Agave Tequilana?
Trichoderma es un hongo benéfico que ofrece una poderosa combinación de bioestimulación y biocontrol. Este microorganismo es clave en la producción sostenible de agave tequilana, gracias a su capacidad de proteger las plantas contra patógenos y promover un crecimiento saludable. A continuación, veamos cómo funciona en cada etapa:
- Al colonizar la raíz, este hongo crea una barrera natural que dificulta la entrada de fitopatógenos como Fusarium (causante de la Marchitez del Agave) y evita que las plagas se adhieran al sistema radicular.
- Mejora la absorción de nutrientes y fomenta un crecimiento vigoroso desde la raíz. Con una raíz más fuerte, la planta se nutre mejor y puede soportar factores de estrés, como cambios en el clima y condiciones adversas del suelo.
- Mejora la microbiota del suelo, favoreciendo un ambiente donde otros microorganismos benéficos pueden prosperar. Esto es clave para mantener la salud del suelo y asegurar la producción a largo plazo.
¿Cómo aumentar el tamaño y peso del Agave con Trichoderma ?
Nuestros productos Fertiatro y Atromix MS han sido formulados para aprovechar al máximo los beneficios de Trichoderma en la producción sostenible de agave azul.
Fertiatro: Agente de Biocontrol
Al aplicarse en la raíz, coloniza el entorno radicular y previene el desarrollo de enfermedades, como la marchitez del agave ocasionado por Fusarium oxysporum.
Esta protección permite que la planta canalice su energía en el crecimiento, sin debilitarse por infecciones o ataques de hongos.
Atromix MS: Bioestimulante Potente

Actúa en las primeras etapas del desarrollo de la planta, potenciando la absorción de nutrientes esenciales y fortaleciendo el sistema radicular.
Además, ayuda a la planta a resistir condiciones de estrés ambiental, como sequías o cambios bruscos de temperatura.
Con el uso combinado de Fertiatro y Atromix MS, los productores pueden proteger y estimular el crecimiento del agave azul desde su base, optimizando el rendimiento del cultivo de forma natural y sostenible.
Claves para Implementar una Producción Sostenible de Agave Tequilana
Si estás buscando alternativas para mejorar la producción de agave tequilana, los bioestimulantes y agentes de biocontrol son aliados clave. Al elegir Fertiatro y Atromix MS, aseguras una producción sostenible que cuida la salud del suelo y optimiza el crecimiento del agave sin dañar el medio ambiente.
¿Por qué no probarlo en tu próximo ciclo de cultivo? Con el respaldo de MVP BioAgro, puedes implementar estas soluciones con la confianza de que estás dando el mejor cuidado a cada planta, desde la raíz hasta el corazón.




